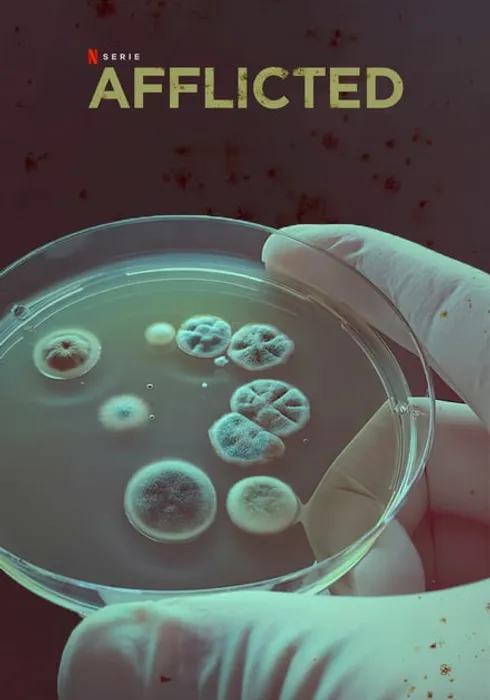

Afflicted
Afflicted
2018 · Netflix · Mystery/Documentary
United States
Baffling symptoms. Controversial diagnoses. Costly treatments. Seven people with chronic illnesses search for answers -- and relief.
Baffling symptoms. Controversial diagnoses. Costly treatments. Seven people with chronic illnesses search for answers -- and relief.